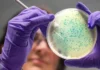
New antibiotics developed using Artificial Intelligence to combat resistant microbes

China marks Lunar New Year with Martial Arts performances by robots
BEIJING: Humanoid robots powered by artificial intelligence (AI) have captured public attention during China’s 2026 Lunar New Year celebrations, showcasing martial arts movements as...
latest news
Dubai introduces robotic technology in construction sector
Dubai: The United Arab Emirates has taken another revolutionary step in Dubai's construction sector by introducing new robotic technology for building homes. According to...
Iran sets conditions for return of International Inspectors to nuclear facilities
TEHRAN: The head of Iran's Atomic Energy Organization has stated that the return of inspectors from the International Atomic Energy Agency (IAEA) is contingent...
Artemis II ready for final pre-launch phase
KABUL: The SLS rocket and Orion spacecraft for the Artemis II mission arrived at Launch Complex 39B at Kennedy Space Center on Saturday. The...